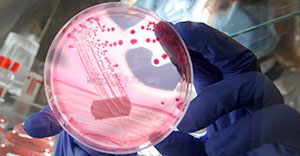

Why rich Chinese students are being kicked out of their Aussie mansions
Property investors from the Asian nation are still demonstrating an insatiable appetite for property, despite this major crackdown. Read more
 KFC feels the heat over ‘nauseating’, ‘disgusting’ and raunchy promotion
KFC feels the heat over ‘nauseating’, ‘disgusting’ and raunchy promotion
Advertising efforts are baffled by the fast food giant’s latest grab for attention, with one saying even ‘a 14-year-old’ would know better. Read more
This will be the single biggest issue in the upcoming election
ANALYSIS: Bill Shorten and Malcolm Turnbull both want to win this particular debate. But the government has a major weakness. Read more
This exaggerated allergy is putting us all at risk of bigger health problems
This exaggerated allergy is putting us all at risk of bigger health problems
A large number of Australians think they’re allergic to this. More than half of them a wrong, according to new research. Read more
Kate Middleton’s wardrobe just reached new, ridiculous heights
Ever wanted to see a grown woman wrangle a baby rhino in high heels? Now’s your chance. See Kate’s insane India tour outfits. Read more
 Popular pasta brand makes stunning admission about its own product
Popular pasta brand makes stunning admission about its own product
They’re so unhealthy, these popular pasta sauces should not be eaten more than once per week, according to the company. Read more
 Hidden tensions the prime minister hasn’t been talking about in China
Hidden tensions the prime minister hasn’t been talking about in China
Australia’s relationship with China isn’t all handshakes and speeches. And this week’s talks are masking some serious problems. Read more
 The unknown Aussie who conquered Hollywood and stole a star’s heart
The unknown Aussie who conquered Hollywood and stole a star’s heart
Lyndall Hobbs befriended some of the world’s most famous people. Now she’s revealed her secrets in a tell-all memoir. Read more
Bad eggs: hefty fines for dodgy ‘free range’ claims by these companies
The ACCC has recorded another victory in its campaign against misleading claims on egg labels. These are the latest brands to fall foul. Read more
 Why protectionism is no longer a dirty word in Australia
Why protectionism is no longer a dirty word in Australia
Japan supports inefficient agriculture, Americans subsidise car-makers. Now, Labor wants us to see steel the same way. Read more
Collingwood coach Nathan Buckley is facing his moment of truth
His team look dispirited, disjointed and unhappy. This is more than a form slump and the Magpies legend is facing the axe. Read more
 Three easy ways to save money on your home renovations
Three easy ways to save money on your home renovations
How much is too much to spend? And where can you minimise costs but not quality? These tips are worth tens of thousands of dollars.Read more















